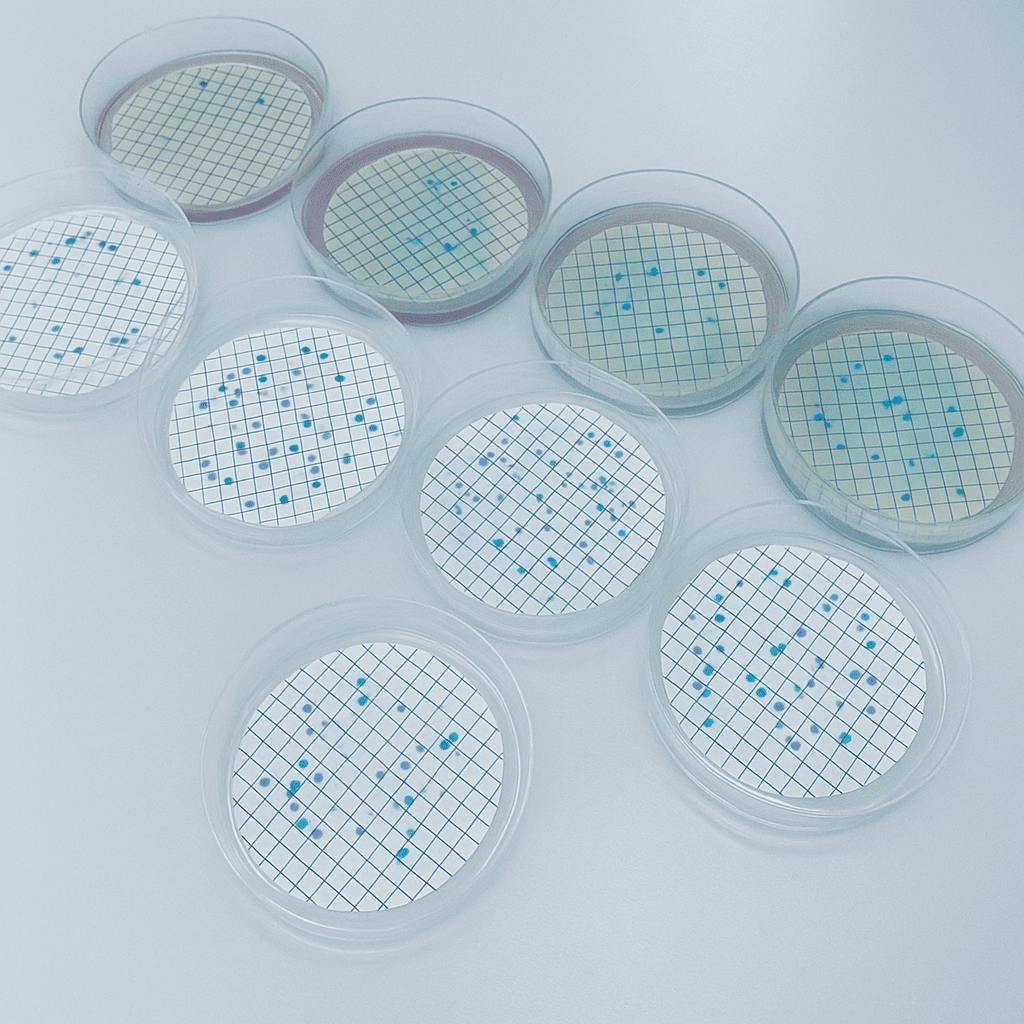
Análisis de microscopio

Avenida de la Trinidad, 61
Apartado Postal 456
38200, San Cristóbal de La Laguna
Santa Cruz de Tenerife - España
Teléfono: (+34) 922 31 92 00
Whatsapp: (+34) 922 31 92 00
Correo electrónico: info@fg.ull.es
Solicitar cita previaInvestigación, servicios y asesoramiento en la calidad biológica de matrices ambientales.
Entre las aplicaciones más frecuentes está en control biológico de muestras de agua de diferente origen, analizando los parámetros incluidos en la legislación vigente. Además, se pueden analizar parámetros adicionales a requerimiento de los clientes.
Por otro lado, se ofrece el análisis de estos parámetros en otro tipo de matrices ambientales (aire, suelos, etc.) y la posibilidad de realizar muestreos in situ para ensayos que requieren el procesado de grandes volúmenes de agua (protozoos entéricos o virus).

NOTA: Realizamos muestreos in situ. Si está interesado/a en alguno de estos servicios, o quiere realizar una consulta sobre otro/s que no figure en este listado, no dude en contactar con el laboratorio.
| Nº | Concepto de los servicios | Tarifas |
|---|---|---|
| 1 | AG-B-01 Detección y recuento de bacterias indicadoras mediante cultivo (Coliformes, E. coli, Enterococos intestinales, Pseudomonas, Clostridium perfringens, etc.) | 13,91€ |
| 2 | AG-B-02 Detección e identificación de bacterias mediante biología molecular | 40,25€ |
| 3 | AG-B-03 Detección e identificación de bacterias patógenas (Legionella, Salmonella, Campylobacter, Vibrio, etc.) mediante cultivo y pruebas bioquímicas | 34,50€ |
| 4 | AI-B-03 Análisis de bacterias en muestras de aire mediante cultivo y/o biología molecular | Consultar |
| 5 | AG-P-01 Análisis de formas de dispersión de helmintos parásitos intestinales en muestras de agua (Método Bailenger modificado RD 1620/2007) | 41,75€ |
| 6 | AG-P-02 Análisis de formas de dispersión de protozoos parásitos intestinales en muestras de agua (regenerada, depurada) mediante inmunofluorescencia directa o biología molecular | 40,25€ |
| 7 | AG-P-03 Análisis de formas de dispersión de protozoos parásitos intestinales en muestras de agua (piscina, potable) mediante biología molecular | 282,01€ |
| 8 | AG-V-01 Análisis de bacteriófagos mediante cultivo en doble capa | 27,83€ |
| 9 | AG-V-02 Análisis de bacteriófagos mediante biología molecular | 40,25€ |
| 10 | AG-V-03 Análisis de virus entéricos en muestras de agua mediante concentración en filtros de carga positiva y biología molecular | 323,70€ |
| 11 | AG-V-04 Análisis de SARS-CoV-2 en aguas residuales según protocolo MITECO | 158,70€ |
| 12 | AI-V-04 Análisis vírico en muestras de aire mediante biología molecular | Consultar |
| 13 | AG-H-01 Análisis de hongos y levaduras mediante recuento en placa | 18,83€ |
| 14 | AG-H-02 Análisis de hongos mediante biología molecular | 40,25€ |
